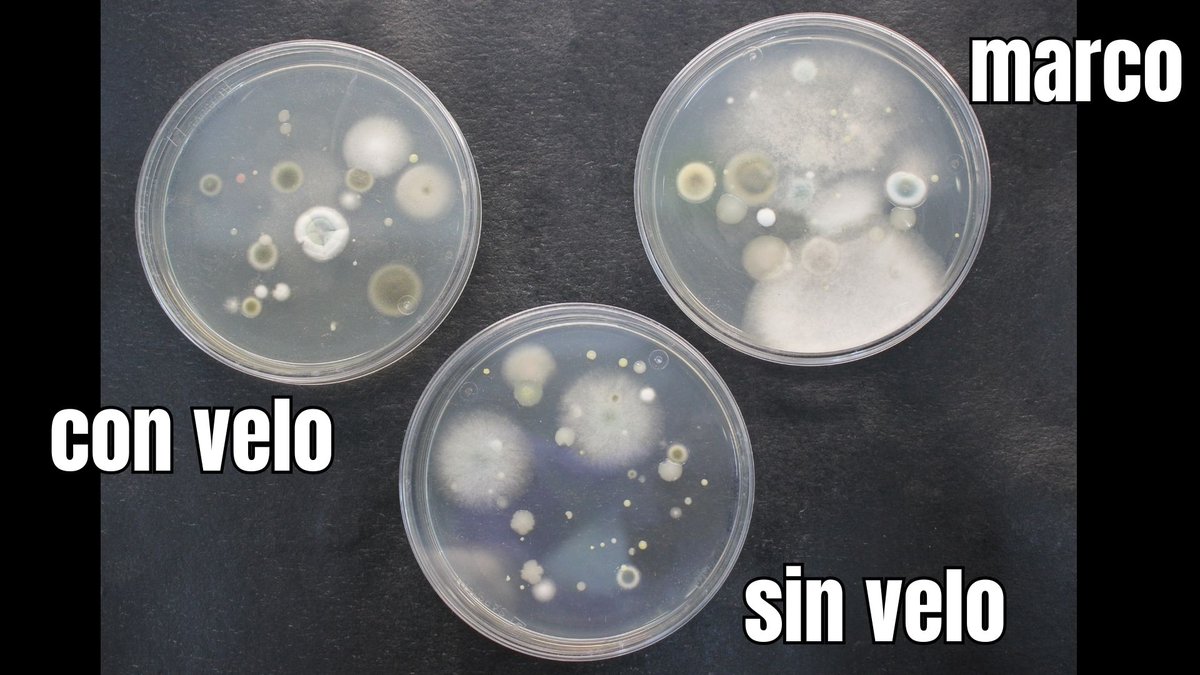
erika tarilonte tweet media

erika tarilonte
30 posts



@Oskar_KimikArte @A_CR_E Con lo chulo que es! ¡Yo tengo el corazón repartido!!
Español

A ver gente, dadle más amor a este hilo para que se sepa que también se investiga en Conservación-Restauración y Arte Contemporáneo
cc @A_CR_E
erika tarilonte@etarilonte
📢📢📢¡Te propongo un juego! Fíjate en las veladuras blancas que hay en este cuadro de arte contemporáneo. ¡¡¡Dentro #HiloTesis!!! @RedDivulga, @filarramendi, @upvehu
Español

Muy interesante hilo de investigación en materiales y deterioros en Conservación Restauración de Arte Contemporáneo.
#CRarteContemporáneo
#Conservación
#Restauración
erika tarilonte@etarilonte
📢📢📢¡Te propongo un juego! Fíjate en las veladuras blancas que hay en este cuadro de arte contemporáneo. ¡¡¡Dentro #HiloTesis!!! @RedDivulga, @filarramendi, @upvehu
Español

📢📢📢¡Te propongo un juego!
Fíjate en las veladuras blancas que hay en este cuadro de arte contemporáneo. ¡¡¡Dentro #HiloTesis!!! @RedDivulga, @filarramendi, @upvehu

Español

También pensamos que podrían ser hongos, ya que la pintura al óleo puede servir de nutriente para ciertos microorganismos, así que muestreamos varias zonas con la ayuda de @ehumicrobiomics y...
GIF
Español

6⃣ Hainbat teknika analitiko erabili ditugu eta hipotesia egokia zela ikusi dugu. Beraz, misterioa argituta: margolanen gainean agertu diren lausodurak berunezko xaboi metalikoak dira! Hurrengo erronka izango da asmatzea nola garbitu xaboi horiek #txiotesia7

Euskara

5⃣ Eta xaboiak balira?
Olio-pintura triglizeridoz eta pigmentuz osatuta dago, eta pigmentu horiek elementu metalikoak badituzte, triglizeridoen gantz-azido askeekin erreakzionatu dezakete xaboi metalikoak osatzeko.
Xaboi naturalak egitean gertatzen den antzera. #txiotesia7

Euskara

1⃣ Margolan garaikide batzuen gainazalean sortzen den substantzia misteriotsua zer den argitzen lagunduko diguzu?
Nire tesiaren izenburua da "Orbegozo Fundazioaren euskal artearen bildumarako prebentziozko kontserbazio-plan bat". Zaharberritzaileok ere ikertzen dugu! #txiotesia7
GIF
Euskara